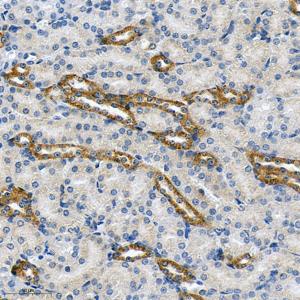
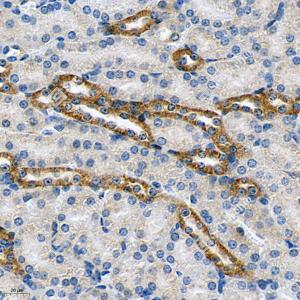
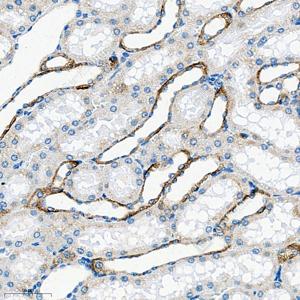

Anti-CaSR Rabbit pAb
- 100 μL
产品信息
|
蛋白质全称 |
细胞外钙敏感受体 |
|
别名 |
Calcium Sensing Receptor, CAR, CASR, FHH, FIH, GPRC2A, HHC, HHC1, NSHPT, PCAR1 |
|
Uniprot ID |
Q9QY96 |
|
免疫原 |
KLH偶联的小鼠CaSR合成肽 |
|
抗体亚型 |
IgG |
|
纯化方式 |
亲和纯化 |
|
亚细胞定位 |
细胞膜 |
应用
| 应用 | 物种 | 稀释 | 阳性样品 |
| IHC/IF 免疫组织化学/免疫荧光 | 人, 小鼠, 大鼠 | 1: 50-1: 150 | 肾 |
背景
CASR, also named as GPRC2A, PCAR1, belongs to the G-protein coupled receptor 3 family. Changes in extracellular calcium are thought to modulate a balance between proliferation and differentiation in a variety of cell types. The activity of CASR is mediated by a G-protein that activates a phosphatidylinositol-calcium second messenger system. It has been shown to play a major role in regulating parathyroid hormone secretion and subsequently influencing the calcium concentration of extracellular fluids.
图像
|
|
IHC检测CaSR蛋白(货号 GB115579). 样品: 人肾, 4%多聚甲醛 (货号G1101) 固定12-24小时. 抗原修复: Tris-EDTA抗原修复液(pH 9.0) (G1203), 98℃, 20分钟. —抗: 1: 150稀释, 4℃ 孵育过夜. 二抗: HRP标记山羊抗兔IgG (H+L) (货号GB23303), 1: 200稀释, 室温孵育1小时. |
|
|
IHC检测CaSR蛋白(货号 GB115579). 样品: 小鼠肾, 4%多聚甲醛 (货号G1101) 固定12-24小时. 抗原修复: Tris-EDTA抗原修复液(pH 9.0) (G1203), 98℃, 20分钟. —抗: 1: 150稀释, 4℃ 孵育过夜. 二抗: HRP标记山羊抗兔IgG (H+L) (货号GB23303), 1: 200稀释, 室温孵育1小时. |
|
|
IHC检测CaSR蛋白(货号 GB115579). 样品: 小鼠肾, 4%多聚甲醛 (货号G1101) 固定12-24小时. 抗原修复: Tris-EDTA抗原修复液(pH 9.0) (G1203), 98℃, 20分钟. —抗: 1: 150稀释, 4℃ 孵育过夜. 二抗: HRP标记山羊抗兔IgG (H+L) (货号GB23303), 1: 200稀释, 室温孵育1小时. |
|
|
IHC检测CaSR蛋白(货号 GB115579). 样品: 大鼠肾, 4%多聚甲醛 (货号G1101) 固定12-24小时. 抗原修复: Tris-EDTA抗原修复液(pH 9.0) (G1203), 98℃, 20分钟. —抗: 1: 150稀释, 4℃ 孵育过夜. 二抗: HRP标记山羊抗兔IgG (H+L) (货号GB23303), 1: 200稀释, 室温孵育1小时. |
储存
| 储存条件 | 在-20℃下储存一年, 避免反复冻融. |
| 储存缓冲液 | 含0.15% ProClin300防腐剂, 100 μg/mL牛血清白蛋白和50%甘油的磷酸盐缓冲液. |
注意:
1.本产品仅供研究使用.
2.建议用一抗稀释液(G2025)稀释本产品.
| 货号 | 名称 | 规格 | 价格 | 操作 |
|---|
| 货号 | 名称 | 规格 | 价格 | 操作 |
|---|